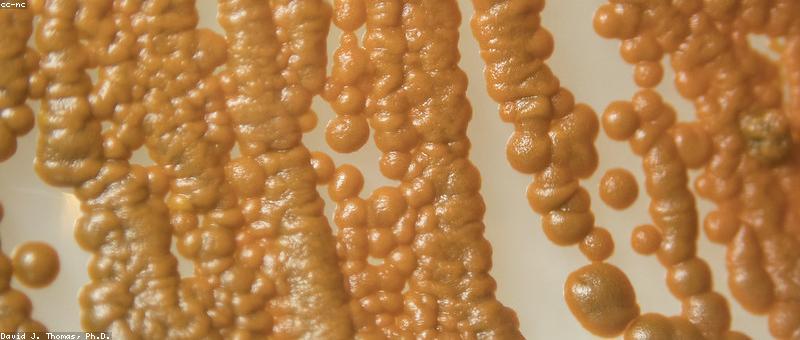

Photosynthesis
photosynthesis sits at the crossroads of history, science, and human curiosity. Here's what makes it extraordinary.
At a Glance
- Subject: Photosynthesis
- Category: Biology, Biochemistry, Plant Science

The Miracle at the Heart of Life
Photosynthesis is a deceptively simple process with profound ramifications for life on Earth. At its core, it is the remarkable reaction that converts light energy from the sun into chemical energy that powers nearly every living organism on the planet. This seemingly mundane metabolic pathway is in fact the foundation upon which the entire global ecosystem is built.
What makes photosynthesis so extraordinary is the sheer scale and complexity of the reaction. Within the cells of green plants, microscopic structures called chloroplasts house the intricate machinery that takes in carbon dioxide, water, and sunlight, and transforms them into glucose and oxygen. This process occurs billions of times every second, releasing oxygen that we breathe and producing the food that sustains us.

The Dawn of Green Life
The origins of photosynthesis can be traced back over 2.5 billion years, to the earliest days of life on our planet. In the primordial oceans, single-celled organisms known as cyanobacteria developed the ability to harness sunlight and convert it into chemical energy. This revolutionary breakthrough was a pivotal moment in the history of life, as it ushered in the "Great Oxygenation Event" - a period when oxygen began accumulating in the atmosphere and paving the way for the evolution of complex aerobic life.
"Photosynthesis is the most important biological process on Earth. Without it, there would be no oxygen in the atmosphere and no food to sustain higher life forms."
The cyanobacteria's innovation of photosynthesis not only transformed the global environment, but also set the stage for the evolution of more sophisticated life forms. Over countless eons, these early photosynthetic organisms were gradually engulfed by other cells, ultimately becoming the chloroplasts that power the photosynthesis of plants today.

The Chlorophyll Advantage
At the heart of the photosynthetic process is a remarkable molecule called chlorophyll. This green pigment, found in the chloroplasts of plant cells, is responsible for the characteristic color of leaves and is the key to unlocking the energy of sunlight.
Chlorophyll molecules are structured in a way that allows them to absorb specific wavelengths of visible light, particularly in the red and blue regions of the spectrum. This selective absorption is what gives plants their green appearance, as the reflected green wavelengths are what our eyes perceive. But more importantly, the absorbed light energy is used to power the complex series of chemical reactions that drive photosynthesis.
The Cycle of Life and Death
The impact of photosynthesis extends far beyond the walls of a plant cell. This vital process is the foundation of the entire food chain, providing the energy and nutrients that sustain virtually all life on Earth. As plants use photosynthesis to produce glucose, they become the primary producers that feed herbivores, which in turn nourish carnivores.
But the cycle doesn't end there. When plants and animals die, their organic matter is broken down by decomposers, releasing the carbon dioxide that is then recycled back into the photosynthetic process. This endless loop of life, death, and rebirth is what keeps our planet's delicate ecosystems in balance.
The Promise of Photosynthesis
As our understanding of photosynthesis has grown over the centuries, scientists have become increasingly fascinated by the potential of this remarkable process. Researchers are exploring ways to harness the power of photosynthesis for a wide range of applications, from creating renewable biofuels to designing more efficient solar panels.
One particularly exciting avenue of research involves engineering plants and microorganisms to produce specialized biochemicals, pharmaceuticals, and even valuable industrial compounds. By understanding the inner workings of photosynthesis at the molecular level, scientists believe they can unlock new ways to sustainably produce the resources we need to support a growing global population.
Comments